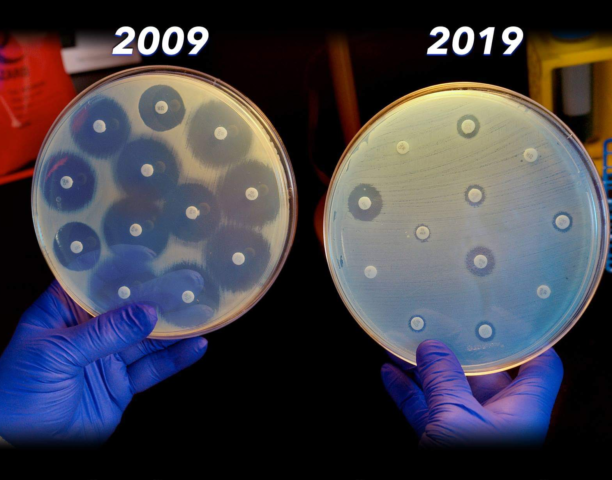

Geomicrobiologi isolano un ceppo di batteri estremofili tra le dune del deserto di Atacama e contro ogni previsione si rivela importante per la produzione di molecole bioattive.
Quegli stessi batteri che combattiamo e che “siamo fatti così” ci ha insegnato a temere potrebbero essere una soluzione a problemi di natura farmacologica.
Batteri sempre più resistenti:
Una delle sfide più complesse e frustranti per i ricercatori biotecnici e farmacologi di tutto il mondo è senza dubbio la necessità di fornire molecole sempre nuove e sempre più efficaci per rispondere alle infezioni batteriche.
Antibiotici che come vecchi amici ci hanno difeso per anni ormai sono divenuti semplicemente inutili a causa della selezione naturale a cui sono stati sottoposti i microrganismi bersaglio degli stessi.
Per fare questo i microbiologi si sono avventurati in posti improbabili e con condizioni di vita durissime per tutti gli organismi, al fine di trovarne di nuovi e mai studiati.
Gli studi iniziati più di 10 anni fa:
Nel 2008, a seguito di ricerche nel deserto di Atacama,viene consegnato a Goodfellow ( microbiologo della Newcastle University) un campione di terreno prelevato da un’area centrale ‘iper-arida’ del deserto, cioè da una zona in cui si suppone non piova da diversi milioni di anni. Una zona da considerare totalmente inospitale.
tuttavia, come è noto è sempre bene non sottovalutare la capacità di adattamento dei batteri.
Da quel campione si riuscì a far crescere una popolazione diversificata di batteri, dando avvio ad un decennio di ricerche sulla fauna microbica del deserto sudamericano.
Il deserto di Atacama infatti è uno dei luoghi più aridi del pianeta a causa della corrente di aria fredda che intercetta le nuvole che eventualmente andrebbero in quella direzione provenienti dal Pacifico e le fa precipitare prima che raggiungano la terra ferma. Possiamo considerare così le regioni centrali completamente irraggiungibili da precipitazioni atmosferiche.

Le molecole di utilità farmacologica:
L’analisi del suolo desertico dell’Atacama, in Cile, ha rivelato un tesoro di batteri che potrebbe aiutare la ricerca scientifica a combattere alcune malattie. A raccontarlo èuno studio pubblicato su Extremophiles nel 2017 e condotto da un team di ricercatori guidato da Juan Asenjo (Universidad de Chile), Alan Bull (Kent University), Michael Goodfellow (Newcastle University) e Marcel Jaspars (Aberdeen University).
In un ambiente così povero infatti la competizione per la sopravvivenza è spietata. I batteri spesso si “equipaggiano” grazie alla selezione naturale di molecole in grado di uccidere microrganismi rivali. Queste molecole posso, se isolate, divenire strumenti, armi da usare contro batteri patogeni.
Nel corso del 2018 quarantasei molecole sono state isolate da alcuni batteri che popolano il deserto più estremo del pianeta, la distesa di dune dell’Atacama. Alcune di queste molecole hanno mostrato importanti proprietà antibiotiche,perfino antivirali e anticancro.
Tra i ceppi prelevati ed isolati infatti spiccavano alcuni actinobatteri, tipologia di batteri da sempre produttrice di molecole farmacologicamente attive come metaboliti secondari. Sono stati un ritrovamento inaspettato ma gradito.
Come hanno fatto a sopravvivere?
Gli actinobatteri sono in grado di produrre spore (alcuni ceppi, non tutti) che gli permette attraverso un processo derivante dalla scissione binaria di sopravvivere alla completa assenza di nutrienti.
Sotto certi aspetti infatti la cellula è come se entrasse in uno stato di “risparmio energetico” totale, dove tutte le funzioni cellulari sono spenta e la cellula con esse.
Nello stato di spora infatti la cellula si disidrata, grazie all’acido dipicolinico che complessa ioni calcio Ca 2+, la sintesi proteica viene spenta ed il DNA viene complessato da strutture proteiche che prevengono danni causati da radiazioni come i raggi UV, che potrebbero causare mutazioni spontanee come dimeri di timidina.
Tuttavia spenta non significa morta e con facilità la cellula può ritornare vitale se le condizioni ambientali lo permettono.
Sede di studi futuri:
Lo studio a pirosequenziamento compiuto sul genoma dei ceppi isolati nel deserto di Atacama ha evidenziato peculiarità e varietà genetiche incredibili, che fanno presupporre una insospettata ampissima varietà di specie isolabili e coltivabili per essere spese nella produzione di molecole bioattive.
Si stima che meno dell’ 1% sia stato isolato, un po’ a causa della difficoltà nell’ottenere campioni, un po’ per una semplice questione di fortuna e probabilmente solo perchè ancora molti luoghi sono sfuggiti al setaccio dei microbiologi.
Le sequenze di genoma provenienti da questi batteri potrebbero essere facilmente inseriti dentro batteri ricombinanti al fine di ottimizzare la resa biotecnologica dal punto di vista industriale. Per questo, studi di genomica e trascrittomica sono estremamente importanti. Per far questo si possono ricorrere a tutto un arsenale di tecnologie molecolari ricombinanti e tecniche di sequenziamento che già da anni sono in uso. Come abbiamo appena visto per studiare la sequenza genetica si è fatto ricorso della tecnica del pirosequenziamento, che prevede l’uso di enzimi in grado di emettere in fluorescenza rilevabile a seguito del legame di un nuovo nucleotide, ad opera della polimerasi DNA dipendente.
tuttavia il processo impiegherà ancora molto tempo , anche solo per gli ostacoli fisici che si frappongono tra i ricercatori e i microorganismi, tuttavia parliamo di un ambiente estremamente variegato e con condizioni altamente selettive per i microorganismi, come elevata salinità, radiazioni a livelli non raggiunti da nessuna altra posizione sul pianeta ed una competizione spietata, stiamo a vedere cosa la natura ha in riserbo per i biologi ed i biotecnici che ci si avventureranno, ne vedremo delle belle.


